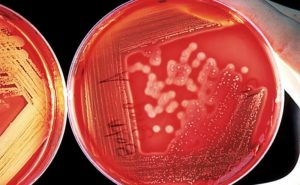
image

Уреаплазмоз — инфекция, передающаяся половым путём (ИППП), и по этому признаку относится к венерическим заболеваниям. Чрезвычайно распространена во всём мире. Страдают и мужчины, и женщины в любом возрасте. До недавнего времени уреаплазма относилась к семейству микоплазмы.
Но после проведенных исследований была вынесена в отдельный подкласс, т. к. выяснилась её способность к уреализу — расщеплению мочевины до аммиака и углерода. Это свойство является пусковым механизмом для образования конкрементов в мочевыводящих путях и развития мочекаменной болезни (МКБ), а также уратного нефролитиаза.
При усиленном размножении уреаплазмы последствия для организма могут быть очень тяжёлыми.
Особенности возбудителя и заболевания
Микроб выявлен в организме каждого человека. Он содержится в некритичных количествах, никаких клинических признаков не проявляет, поэтому относится с некоторых пор к условно-патогенной микрофлоре.
Если при воздействии каких-либо неблагоприятных факторов, приводящих к снижению иммунитета, уреаплазма начинает стремительно размножаться, возникают симптомы воспаления.
У женщин инфекция протекает остро, с яркими клиническими проявлениями.
Чтобы понять, последствия уреаплазмоза у женщин, необходимо знать, что 60% женщин являются носителями, и только у 30% из них она проявляется клинически. В остальных случаях это — бессимптомное носительство, которое при определённых обстоятельствах может стать активной болезнью, и если не начать лечение, быстро развиваются тяжёлые осложнения.
Но диагностируется гораздо реже в связи с бессимптомным носительством и отсутствием в течение длительного времени признаков болезни.
По этой причине в медицинских кругах уже долгие годы идёт дискуссия: опасно ли носительство уреаплазмы.
Патогенными для людей являются только два вида — Ureaplasma urealyticum и Ureaplasma parvum. Они объединены в общую группу — Ureaplasma species (spp).
Так же, как и микоплазмы, являются промежуточными микроорганизмами между вирусами и бактериями. Отсутствие клеточной стенки, мельчайшие размеры (может проходить через поры презерватива) и внутриклеточное паразитирование роднят их с вирусами, а наличие некоторых клеточных органелл и чувствительность к определённым видам антибиотиков делает похожими на бактерии.
Уреаплазма, не имея собственной оболочки, прикрепляется к лейкоцитам, к клеткам эпителия слизистой оболочки мочеполовых путей, разрушая их.
У мужчин может присоединяться ещё и к сперматозоидам, что ведёт к снижению их активности, уменьшает вязкость, изменяет форму.
В мазке уреаплазма у женщин встречается намного чаще, чем у мужчин, поэтому вопрос, чем опасен уреаплазмоз у женщин, волнует многих.
Какие осложнения могут возникнуть у мужчин и женщин
На основании исследований, которые проводились по изучению микроорганизма, стало ясно, чем опасна уреаплазма.
Женщин инфекция поражает в два раза чаще, чем мужчин. Это во многом связано с анатомическими особенностями женского организма: короткой и широкой уретрой (в отличие от мужской — извилистой и узкой), по которой патологические агенты проникают в верхние отделы мочеполовой системы.
При сниженном иммунитете в результате стрессов, переохлаждений, сопутствующих заболеваний, беременности, хирургических вмешательств развиваются симптомы уреаплазмы. У мужчин поражаются уретра, мочевой пузырь, простата и яички. У женщин, помимо уретры — матка, придатки и влагалище.
При этом появляются следующие симптомы:
- болезненность, рези и ощущение жжения при мочеиспускании;
- дискомфорт и боли во время полового акта;
- слизистые (или с примесью крови у женщин) выделения в конце мочеиспускания;
- тяжесть в яичках у мужчин, болезненность в нижней части живота у женщин.
Бесплодие у мужчин
Последствия уреаплазмоза у мужчин очень тяжёлые. Если своевременно не обратиться при первых признаках болезни за консультацией, исход будет неприятным — развивается бесплодие.
Это связано с непосредственным паразитированием уреаплазмы внутриклеточно, в т. ч. внутри сперматозоидов.
Опасность уреаплазмоза у мужчин выясняется спустя некоторое время после того, как болезнь после скрытого течения, когда длительное время симптомы отсутствуют, проявится своими осложнениями.
Протекает бессимптомно у 80% мужчин, и обращения с описаниями жалоб происходят уже на стадии осложнений. Это может произойти спустя много месяцев после заражения.
Но у людей с резко сниженным по какой-либо причине иммунитетом развёрнутая клиническая картина может проявиться спустя 2 недели после инфицирования: происходит стремительное размножение микроорганизмов и результат их влияния выражается в немногочисленных, но неприятных жалобах:
- сильные рези во время мочеиспускания;
- частые позывы;
- затруднённое мочеиспускание;
- боль в области уретры;
- нарушение эрекции.
Нарушение сперматогенеза
Последствие воздействия уреаплазмы на организм выявляется при обследовании, которое проводится часто по поводу других заболеваний, либо при невозможности наступления беременности у женщины (в этом случае анализы должны сдавать оба партнера). Самое тяжёлое осложнение, которое возникает в результате жизнедеятельности в организме уреаплазмы — бесплодие.
У мужчин происходит нарушение сперматогенеза, меняется:
- количество (олигоспермия — в результате апоптоза клетки саморазрушаются, их число резко уменьшается);
- строение сперматозоидов (возникают клетки с патологически изменённой формой);
- подвижность (астеноспермия — сперматозоиды становятся «медленными»).
Кроме того, снижается эректильная функция мужчин, подавляется общая резистентность организма. Уреаплазма влияет не только на урогенитальную систему, но и на другие органы: часто развиваются менингиты, пневмонии, инфекционные артриты. Лечение длительное, дорогостоящее, т. к. придётся проходить лабораторную диагностику для контроля качества терапии.
Кроме бесплодия часто возникает патология мочевыводящих путей, включая нередко развивающуюся мочекаменную болезнь, уретриты, воспаления половых путей.
Симптомы при данной инфекции, в зависимости от степени поражения, мучительны, требуют тщательного лечения антибиотиками. На весь период приёма антибактериальной терапии необходимо отказаться от половой жизни, соблюдать строгую диету, ограничить пребывание на солнце, вовремя сдавать анализы. Соблюдать эти правила нужно всем половым партнёрам.
Проявления уреаплазмоза у женщин
Клинические проявления наблюдаются при остром течении. Если процесс вялотекущий и хронический, всё может протекать незаметно для женщин. Период инкубации составляет около 3 недель.
Появляется частое мочеиспускание, сопровождающееся зудом и жжением, возможна сыпь на коже, боли в правом подреберье. Также характерны частые простуды, эрозии шейки матки с гнойными выделениями, боли в суставах, воспаление мочеиспускательного канала.
При оральном сексе поражается слизистая ротовой полости. Может появиться гиперемия, эрозии на слизистой, боли и жжение во рту, усиливающиеся при употреблении сильно горячей или холодной пищи, а также острой еды и газированных напитков.
Данные процессы наиболее актуальны в период вынашивания плода.
Из-за сниженного иммунитета происходит активное размножение уреаплазмы.
Если женщина являлась носителем небольшого количества уреаплазмы, при отсутствии лечения после зачатия активно развивается уреаплазмоз с развёрнутой клинической картиной и всеми осложнениями.
Влияние уреаплазмы на процесс беременности
У женщин, помимо воспалительных заболеваний — уретрита, кольпита, аднексита — может возникнуть внематочная беременность, т. к. уреаплазма обитает в придатках матки, вызывая воспаление. Развивается спаечный процесс в трубах и уплотнение капсулы яичников.
Без лечения уреаплазмоз может привести к полной обтурации (непроходимости) маточных труб — зачатие и беременность становятся невозможными, что влечёт за собой женское бесплодие.
В некоторых случаях удаётся восстановить их проходимость путём оперативного вмешательства, но иногда проблема неустранима.
При уже наступившей беременности нередко происходит инфицирование плода и плодных оболочек. Это приводит к резкому снижению веса плода, возможно наступление преждевременных родов, развитие пневмонии у новорождённых. Существует опасность выкидыша. Встречается нечасто, в основном, у женщин с иммунодефицитом.
На раннем сроке беременности у плода может развиться серьёзное осложнение уреаплазмоза в виде бронхолёгочной дисплазии. Это приводит к тому, что плод перестаёт развиваться, останавливается в своём формировании, беременность становится «замершей».
Это происходит в случае инфицирования оболочек плода и околоплодных вод. Тяжесть последствий, дальнейшая патология у ребёнка зависит от срока, на котором произошло инфицирование. Но в любом случае ребёнок появляется с врождённым уреаплазмозом.
Это один из вариантов вертикального пути заражения.
Ещё один из видов патологии — фетоплацентарная недостаточность. Инфекция, воздействуя на сосуды плаценты, становится угрозой для беременности, вызывая недостаток питательных веществ и кислорода у плода. Результатом является рождение недоношенных или незрелых детей.
Реактивный артрит
Реактивный артрит развивается примерно через две недели после заражения. Начинается с поражения коленных, локтевых, межфаланговых суставов стоп. Возникают все симптомы воспаления: боль, отёк, гиперемия.
Позже в патологический процесс вовлекаются кисти. Артрит сопровождается клинической картиной развивающегося уретрита. Одновременно могут появиться боли и жжение в глазах, их покраснение, слезотечение, нарушение зрения.
Это проявления конъюнктивита.
Диагноз реактивного артрита, вызванного уреаплазмой, выставляется при получении положительных анализов на инфекцию.
Лечение назначается одновременно обоим половым партнёрам, иначе терапевтический процесс будет неэффективным — повторится рецидив.
Необходимость диагностики
Для определения степени опасности заболевания для женщины и ребёнка нужна специальная диагностика. Если женщина уже ждёт ребёнка, но не обследовалась на уреаплазму, лабораторные анализы можно проводить только при наличии веских подозрений на инфекцию.
Если уреаплазма была определена у женщины и успешно пролечена, то планирование беременности возможно только через 3 месяца после проведенного курса лечения. Это время необходимо, чтобы организм полностью освободился от лекарственных препаратов, способных оказать негативное воздействие на плод.
Нельзя ставить себе самостоятельно диагноз и заниматься самолечением. У мужчин и у женщин это может закончиться серьёзными, порой непоправимыми последствиями. Необходимо обязательно обращаться к врачу для своевременной диагностики и лечения. Только в таком случае удастся избежать негативных последствий.
Симптомы и лечение уреаплазмоза
Уреаплазмоз – инфекционное заболевание, которое передаётся половым путём, имеет специфические проявления у мужчин и женщин. Без правильной диагностики и надлежащего лечения развиваются тяжелые осложнения, но если начать терапию вовремя, можно быстро избавиться от болезни.
Что такое уреаплазмоз?
Уреаплазмоз – венерическое заболевание, возбудителями которого являются ureaplasma urealyticum и ureaplasma parvum, внутриклеточные паразиты занимают промежуточную позицию между вирусами и бактериями, своё название получили за способность расщеплять мочевину, как они выглядят под микроскопом, можно увидеть на фото.
Причины возникновения и пути передачи
Уреаплазмоз – ИППП, инфекция проникает в организм половым путём при незащищенном генитальном и оральном половом акте, можно заразиться и при поцелуях, если во рту присутствуют язвочки, кариозные зубы.
Существует и вертикальный способ заражения – болезнь передаётся от матери к ребёнку во время прохождения по родовым путям, инфекция опасна для новорождённого, поэтому необходимо сдавать анализы на уреаплазму на этапе планирования беременности.
Использование презерватива на 100% защищает от заражения урогенитальном уреаплазмозом.
Симптомы уреаплазмоза у женщины и мужчин
После заражения микроорганизм поражает слизистую простаты и уретры у мужчин, уретру и влагалище и женщин, проявляются различные уреаплазменные инфекции. Инкубационный период при ослабленных защитных функциях организма – 4–30 суток, при сильном иммунитете болезнь бессимптомно может протекать долго.
Основные признаки патологии
| Уреаплазмоз у мужчин | Уреаплазмоз у женщин |
|
|
К какому врачу обратиться?
При появлении специфических признаков уреаплазмоза необходимо посетить уролога, гинеколога, венеролога, дерматовенеролога.
Диагностика уреаплазмы
Клиническая картина уреаплазмоза не специфична, схожа со многими заболеваниями мочеполовой системы, поэтому диагностировать её можно только после лабораторного обследования. Чаще всего при болезни появляются слизистые прозрачные выделения, могут присутствовать примеси гноя, они имеют резкий запах аммиака, наблюдается воспалительный процесс слизистых уретры и влагалища.
Основные методы диагностики:
- ИФА – иммуноферментный анализ считается наиболее информативным и достоверным методом для выявления уреаплазмоза, показывает наличие антител к возбудителям заболевания. Позволяет определить вид, количество микроорганизмов, степень и давность заражения.
- Реакция прямой и непрямой иммунофлюоресценции – при помощи специальных реактивов под микроскопом выделяют наличие в крови антител к уреаплазме.
- ПЦР – в крови обнаруживают ДНК уреаплазмы, анализ делают быстро, он отличается высокой чувствительностью, позволяет определить примерное количество патогенных микроорганизмов.
- Посев мазка из уретры, влагалища, простаты – уреаплазму обнаружить таким способом нельзя, но эта инфекция практически всегда сопровождается другими венерическими заболеваниями.
- Анализ на чувствительность к антибактериальным препаратам.
За 2 дня до сдачи анализов необходимо избегать половых контактов, прекратить применять свечи, гели и другие средства для вагинального введения, нельзя делать спринцевание, использовать тампоны. Водные процедуры нужно проводить вечером перед посещением врача, мыло лучше не использовать, в день сдачи анализов подмываться нельзя.
Пограничным считается титр уреаплазмы 10 в 4 степени, при его повышении подтверждается наличие уреаплазменных инфекции.
Лечение уреаплазмоза
Терапия при уреаплазмозе направлена на устранение патогенных микроорганизмов, укрепление иммунитета, снижения риска рецидива заболевания. Лечение необходимо проходить обоим партнёрам одновременно, до полного излечения любые половые контакты запрещены.
Эффективные препараты
Основу терапии при уреаплазмозе составляют антибактериальные препараты, в качестве дополнительных лекарств назначают средства для укрепления иммунной системы, восстановления баланса микрофлоры.
Чем лечить уреаплазмоз:
- антибактериальные препараты быстрого действия – Левофлоксацин, Азитромицин, позволяют избавиться от инфекции за 3–4 дня;
- антибиотики широкого спектра действия – Доксициклин, Кларитромицин, Эритромицин, Метронидазол;
- иммуномодуляторы – Иммунал, индукторы интерферона, настойка эхинацеи, зверобоя;
- пробиотики – Линекс, Хилак форте.
Одним из современных методов лечения уреаплазмоза считают биорезонансную терапию – коррекция работы внутренних органов при помощи электромагнитных колебаний.
Как долго лечится уреаплазма?
Схема, продолжительность лечения зависит от степени тяжести и формы заболевания, если начать лечить острый уреаплазмоз сразу после появления первых признаков, избавиться от болезни можно за 10–14 дней.
Возможные последствия и осложнения
Если не остановить активный рост уреаплазмы, микроорганизмы начнут заселять мочевыводящие и половые пути, что грозит развитием различных осложнений.
Чем опасен уреаплазмоз:
- по мере развития заболевания поражается матка, маточные трубы, развивается эндометрит, аднексит, воспаление органов малого таза;
- при наличии уреаплазмы увеличивается риск развития послеродового, послеабортного эндометрита, лихорадки;
- цервикальная недостаточность;
- импотенция, ухудшение качества спермы – следствие хронического уреаплазменного простатита;
- мочекаменная болезнь;
- аутоиммунные ревматические заболевания – развиваются на фоне запущенного уреаплазмоза.
Самое опасное последствие уреаплазмоза – бесплодие, развивается в равной степени и мужчин и женщин при отсутствии правильной антибактериальной терапии.
Уреаплазмоз при беременности
При наличии уреаплазмы поражается эндометрий матки, поэтому нормальное зачатие, внутриутробное развитие ребёнка невозможно, даже если яйцеклетка закрепиться в полости матки, риск выкидыша составляет практически 100%.
Основные осложнения уреаплазмоза при беременности:
- преждевременные роды – ребёнок рождается слабым, недоношенным, при естественном родоразрешении риск инфицирования новорожденного составляет 50%;
- нарушение маточно-плацентарного кровообращения;
- гипоксия, внутриутробная задержка развития;
- у новорожденных уреаплазма может вызвать пневмонию, сепсис, менингит, бронхолёгочную дисплазию.
Раньше если уреаплазму обнаруживали во время беременности, женщине рекомендовали сделать аборт, но среди современных антибиотиков есть безопасные препараты, которые можно применять для лечения будущих мам, но большинство из них можно использовать только во II триместре, поэтому лучше пройти диагностику, пролечиться заранее.
Уреаплазмоз во время беременности часто становится причиной преждевременных родов.
Профилактика инфекции
Чтобы избежать заражения или активного роста уреаплазмы, необходимо избегать случайных половых связей, пользоваться барьерными средствами контрацепции, укреплять иммунную систему.
При появлении признаков заболевания необходимо пройти лечение полностью, нельзя прерывать курс раньше, если исчезли основные проявления инфекции.
Отзывы
Katyshka
«Обнаружили уреаплазму, титр 10 в 3 степени, врач прописал 2 антибиотика, ещё много всяких лекарств. Я решила для начала укрепить иммунитет – пропила витамины, начала проводить закаливающие процедуры, больше времени проводила на свежем воздухе. Через месяц анализы были отрицательными, избавилась от болезни безо всякой химии».
Feya_Vesna
«Полгода назад у меня обнаружили уреаплазмоз, молочницу, эрозию шейки матки, лечилась Метронидазолом, пила витамины, пробиотики, через месяц все неприятные симптомы исчезли. Я замужем, спросила у гинеколога, нужно ли лечить мужа, врач сказал, что нет. В итоге сейчас у меня обострение уреаплазмоза, придётся начинать лечение повторно, уже вместе с мужем».
Lora79
«От уреаплазмы страдаю уже несколько лет – лечилась и антибиотиками, настойкой матки боровой и красной щётки, симптомы исчезали лишь ненадолго. Вылечиться мне удалось только при помощи биорезонансной терапии».
Уреаплазмоз вызывает много споров на счет лечения: одни рекомендуют не лечить болезнь, а заняться укреплением иммунитета, другие настаивают на незамедлительной антибактериальной терапии.
Уреаплазма – условно-патогенный микроорганизм, который начинает активно размножаться на фоне ослабления защитных функций организма, к инфекции часто присоединяются другие воспалительные процессы. Как лечить заболевание? Выбор остаётся за пациентом, можно проконсультироваться с несколькими специалистами, принять решение.
Уреаплазмоз — причины, признаки, симптомы и лечение, как передается уреаплазмоз человеку
Уреаплазмоз очень широко распространен, являясь одной из наиболее часто встречающихся инфекций, передающихся половым путем (ИППП).
Возбудитель этого заболевания – микроорганизм уреаплазма, относящийся к внутриклеточным микробам.
Под уреаплазмозом подразумевают наличие воспалительного процесса в мочеполовой системе, при котором, в ходе лабораторных исследований, выявляется уреаплазма и не обнаружен другой возбудитель.
Что это за болезнь, основные причины и признаки, а также способы лечения — рассмотрим в этой статье.
Что такое уреаплазмоз?
Уреаплазмоз — это заболевание, характеризующееся воспалительными процессами в органах мочеполовой системы, вызванное условно-патогенным микроорганизмом — уреаплазмой (Ureaplasma urealyticum).
Уреаплазма – это микроскопический микроорганизм способный к внутриклеточному паразитированию. В настоящее время наблюдается стойкая тенденция к росту числа выявляемых случаев инфицирования.
Наряду с этим наблюдается преимущественно единовременное инфицирование несколькими видами половых инфекций: гонорея, микоплазма, уреаплазма, хламидиоз. Потому симптоматика заболевания может видоизменяться.
Наиболее благоприятным фактором развития уреаплазмоза является снижение иммунитета, что может быть вызвано низкокачественным и недостаточным питанием, вредными привычками, перенесенным вирусным заболеванием, нервными расстройствами и постоянными стрессами, применением антибактериальных и гормональных препаратов, радиоактивным облучением.
Видов уреаплазм существует множество, но наиболее значимых из них два:
- Ureaplasma urealyticum (Уреаплазма уреалитикум),
- Ureaplasma parvum (Уреаплазма парвум).
Причины
Уреаплазмоз вызывается бактерией, внутриклеточным паразитом. Из за своих малых размеров данная бактерия занимает промежуточное состояние между бактериями и вирусами. Однако она охотно колонизирует слизистые половых органов.
Бытовое инфицирование уреаплазмозом маловероятно, как правило, взрослые люди заражаются при половых контактах. Носителями уреаплазм являются около 50% женщин, процент зараженных мужчин значительно меньше и у представителей сильного пола возможно самоизлечение. Кроме того, инфицирование уреаплазмозом может произойти во время родов от матери к ребенку.
Основные причины, провоцирующие ускоренное размножение уреаплазм:
- снижение иммунитета,
- иммунодефицитные состояния,
- частая обработка половых органов антисептиками (хлоргексидином, мирамистином),
- приём антибиотиков,
- использование интравагинальных свечей с антибиотиками или антисептиками,
- наличие других половых инфекций,
- частая смена сексуальных партнёров.
Как передается уреаплазмоз?
Уреаплазмоз проявляется не сразу, не беспокоя человека долгое время. Из-за этого носитель заболевания может даже и не знать о нем и продолжает заражать половых партнеров длительный период. Инкубационный период уреаплазмоза составляет 2-4 недели.
Основными путями передачи Ureaplasma spp считаются незащищенные половые контакты, и заражение младенцев от матери внутриутробно или в процессе прохождения через родовые пути.
Если инфекция проникла половым путём, то инкубационный период зависит от состояния организма заражённого, в среднем примерно около месяца. Однако инфицирование не всегда приводит к развитию заболевания. Уреаплазма годами способна жить в организме человека, не вызывая никаких неудобств и симптомов заболевания.
Симптомы уреаплазмоза у взрослых
Длительное время уреаплазма может не давать о себе сигналов, находясь в неактивной форме годами. Обострения чаще всего связаны с внутренними перестройками организма, например с беременностью, или приемом гормональных препаратов. Симптоматика аналогична многим ЗППП, поэтому пробовать поставить диагноз самостоятельно не стоит.
Основные признаки уреаплазмоза:
- жжение в мочеиспускательном канале, переходящее в зуд;
- белёсые мутноватые выделения из половых органов (обычно по утрам);
- режущие ощущения при мочеиспускании.
| Уреаплазмоз | Симптомы |
| У женщин |
|
| У мужчин |
|
Последствия
Кажущаяся несерьезность заболевания обманчива. Последствиями уреаплазмоза становится целый ряд проблем, часто наносящих непоправимый вред здоровью:
- хроническое воспаление органов половой системы;
- цистит;
- пиелонефрит, чаще хроническая форма;
- мочекаменная болезнь у мужчин и женщин;
- бесплодие как одного, так и второго партнера;
- эректильные дисфункции и простатит у мужчин;
- импотенция;
- различные патологии беременности, включая внематочное развитие и выкидыши на любом сроке;
- общее разрушение иммунной системы, провоцирующее развитие других заболеваний.
Не следует рассматривать наличие в организме уреаплазмы и в качестве основной причины бесплодия.
На возможность забеременеть влияет не сам факт присутствия возбудителя, а наличие воспалительного процесса.
Если таковой имеется, то следует незамедлительно провести лечение, причем обязательно совместно со своим постоянным половым партнером, ведь уреаплазмоз нарушает и репродуктивную функцию мужчин.
Диагностика
Диагностика уреаплазмоза не представляет слишком большой сложности для современной медицины.
Посещению врача должна предшествовать подготовка:
- За 2 дня до приема у врача необходимо воздержаться от каких бы то ни было половых контактов
- В течение 2-х дней перед осмотром необходимо прекратить использование любых вагинальных свечей, гелей и прочих препаратов вводимых вагинально.
- Необходимо прекратить спринцевания, использование влагалищных тампонов.
- Накануне посещения врача вечером стоит подмыться теплой водой желательно без использования мыла.
- В день обращения подмывания противопоказаны.
Для достоверной лабораторной диагностики уреаплазмоза сегодня применяют комбинацию из нескольких методов, подбираемых врачом. Обычно используется несколько методик для получения более точных результатов:
- Серологический метод (обнаружение антител). Данный метод диагностики назначается для выявления причин выкидыша, бесплодия, а также заболеваний воспалительного характера в послеродовом периоде.
- Культуральное исследование: посев на питательные среды микроорганизмов. Через неделю подсчитывают рост колоний и делают заключение: больше 10 в 4 степени КОЕ на мл — диагностически значимое количество уреаплазм, меньше — диагностически не значимое. Также с помощью этого анализа определяют чувствительность к антибиотикам.
- Полимеразная цепная реакция (ПЦР). Довольно дорогой метод. С его помощью можно определить даже незначительное количество бактерий или вирусов в сыворотке крови задолго до клинических проявлений болезни.
- Иммунофлюорисценция (РНИФ — непрямая, РПИФ — прямая). Один из самых недорогих методов выявления патогенной микрофлоры.
- Иммуноферментный анализ (ИФА) обнаруживает антитела к белкам уреаплазмы. Процедура позволяет решить, какая инфекция провоцирует болезни мочеполовой сферы и правильно лечить патологию. С помощью метода можно провести дифференциальную диагностику и определить титр (количество микроорганизмов в крови).
Обследование и лечение по поводу уреаплазмоза нужно пройти и половому партнеру, даже если у него нет никаких жалоб.
Лечение уреаплазмоза
Лечение, как правило, проводится амбулаторно. Возбудитель этого заболевания очень легко приспосабливается к различным антибиотикам. Порой, даже несколько курсов лечения оказывается недейственными, потому что найти нужный антибиотик бывает чрезвычайно трудно. Помочь в выборе может посев уреаплазм с определением чувствительности к антибиотикам.
Важным условием успешной терапии является лечение уреаплазмоза у обоих партнеров. Основные методы включают в себя:
- применение антибактериальных медикаментов;
- назначение иммуномодуляторов;
- использование средств для местного лечения;
- физиотерапия.
Антибиотики
Основными средствами в лечении уреаплазмоза считаются антибиотики. Их применяют местно в виде гелей, мазей, растворов, вагинальных свечей, принимают перорально и возможны даже внутривенные инфузии, улучшающие биодоступность препарата и создающие возможность избежать многих побочных эффектов, связанных с прохождением антибиотика через печень при приеме таблеток.
Лечение антибактериальными медикаментами проводится в соответствии с чувствительностью к ним присутствующих в организме микробов. На уреаплазмы действуют антибиотики следующих групп:
- макролиды – средства «Кларитромицин», «Эритромицин», «Олеандомицин» и другие;
- препараты тетрациклинового ряда;
- противогрибковые средства;
- линкозамины – «Клиндамицин», «Далацин»;
- противогрибковые медикаменты.
Восстановление нормальной микрофлоры
Интенсивное применение антибактериальных препаратов при уреаплазмозе воздействует не только на уреаплазмы, но и на полезные микроорганизмы, необходимые для подавления роста патогенной микрофлоры. Потому восстановление нормального биоценоза половых путей является необходимым условием выздоровления.
С этой целью назначается прим препаратов эубиотиков:
- хилак форте,
- линекс,
- бифидумбактерин,
- ацилакт.
Иммуномодуляторы
Также больному с уреаплазмозом назначают иммуномодуляторы (тималин, таквитин, лизоцим, де-карис, метилурацил). В качестве иммуномодулятора можно применять экстракт элеутерококка и пантокрин. По окончанию курса лечения, больному назначаю витамины В и С, бифидум- и лактобактерин, гепатопротекторы (стимуляция функции печени и желчного пузыря).
Соблюдайте правильное питание
Диета имеет целью повысить защитные силы организма и должна содержать необходимое количество углеводов, белков, жиров, полезных витаминов и микроэлементов.
Основной целью диеты в данном случае становится укрепление защитных сил организма, поэтому пища, составляющая основу рациона, обязательно должна содержать достаточное количество белков, жиров и углеводов, а также витаминов и полезных микроэлементов.
- Очень важно на время лечения уреаплазмоза воздержаться от употребления спиртных напитков, даже самых слабых, ведь антибиотики и алкоголь абсолютно несовместимы.
- Помимо этого необходимо значительно ограничить, а лучше и вовсе исключить жирную, острую и соленую пищу, а также копчености и маринады.
- Кроме того, не рекомендуется употреблять сладкое и мучное в больших количествах.
Пройдя полный курс лечения человек обязательно должен сдать анализы еще раз. Если болезнь не отступила полностью, то лечат уреаплазму уже с учетом того, что бактерии выработали устойчивость к препаратам, принимаемым ранее.
Как лечить народными методами?
Лечение уреаплазмоза народными средствами пользуется популярностью среди населения, ведь широко известны травы и растения, экстракты которых оказывают антибактериальный и противовоспалительный эффект. Однако необходимо понимать, что лекарственные экстракты не всегда достаточно действенны по отношению к высоким концентрациям патогенных микроорганизмов.
- При зуде и жжении для подмываний используется отвар коры дуба, такое средство снимает дискомфорт и способствует уничтожению бактерий.
- При симптомах уреаплазмоза корень солодки, копеечника, шишки ольхи и траву череды в равных частях измельчают, перемешивают между собой. Полученный сбор заливают пол литрами кипятка и настаивают в термосе 12 часов. Необходимо принимать народное средство для лечения по полстакана 3 раза в день.
- Целый ряд лекарственных трав, которые долгое время в народной медицине называли женскими, также дает положительный результат для лечения уреаплазмоза. Это грушанка, боровая матка, золотарник, зимолюбка. Их используют и для составления чайных сборов, и для внешнего применения.
- Цветки мать и мачехи, льна, сабельника и листья маслины берется в равных пропорциях, сушат, измельчают и заливают на 12 часов литром кипятка, настаивают. Принимать при симптомах уреаплазмоза такое средство три раза в день по половина стакана.
- кора дуба (две части), корень бадана (одна часть), боровая матка (одна часть), курильский чай (одна часть): 20 грамм сбора на один стакан кипятка, кипятить под крышкой на медленном огне в течении 20 минут, настаивать два часа, использовать для наружной гигиены половых органов и спринцевания.
Рекомендации при уреаплазмозе
Важным условием полного выздоровления и его закрепления являются прописанные дерматовенерологом следующие мероприятия:
- прием препаратов для поддержания желчного пузыря и печени;
- массаж предстательной железы (для мужчин с диагнозом «простатит»);
- прием препаратов, повышающих функции иммунной системы;
- соблюдение правильного режима жизни (полноценный отдых и питание);
- применение таблеток, восстанавливающих микрофлору кишечника.
Профилактика
Что же нужно делать, чтобы не и инфицироваться уреаплазмозом, а если инфицирование произошло, то что нужно предпринимать, чтобы избежать осложнений?
- Снижение или исключение случайных половых контактов.
- При случайных половых контактах (вне зависимости от вида контакта) необходимо использовать индивидуальные барьерные средства защиты.
- Лечение должно быть комплексным и увенчаться отрицательным результатом контрольного теста.
- Поддержание иммунитета на высоком уровне позволит справиться с этой инфекцией организму самостоятельно.
Уреаплазмоз — опасное воспалительное заболевание, которое несет за собой неприятные симптомы и последствия. Лечить недуг нужно своевременно при возникновении хотя бы малейшего симптома, свойственного уреаплазмозу. Только тогда можно исцелить болезнь и избежать таких осложнений, как бесплодие.
Лечить ли уреаплазмоз
Нужно ли лечить уреаплазмоз у женщин и мужчин, часто спрашивают пациенты, столкнувшиеся с этим диагнозом.
Ведь всем известно, что уреаплазма – это представитель условно-патогенной микрофлоры. Это означает, что заболевание она вызывает далеко не всегда.
Норма ли это – обнаружить в анализах положительный уреаплазмоз и, если это патология, то как избавиться от нее?
И народными средствами и с помощью традиционной терапии, часто интересуются больные.
Можно ли обойтись без антибиотиков, и в каких случаях лечить уреаплазмоз у мужчин и женщин причин нет?
Уреаплазмоз: как заражаются патологией
Попробуем разбираться с тем, норма ли наличие уреаплазмы в человеческом организме, Сначала необходимо понять, какими путями патогенный микроорганизм попадает в тело человека. Вариантов несколько. Наиболее часто встречающийся и, соответственно, наиболее значимый путь передачи – половой.
У партнера, зараженного болезнью, могут полностью отсутствовать какие-либо симптомы и жалобы. Но при этом заражение при сексуальных контактах без защиты все равно возможно, так как бактерия присутствует в организме. Далее возможны два сценария.
Либо зараженный человек сам становится носителем, но при этом уреаплазмоз ничем себя не проявляет. Либо, если иммунитет низкий, появляются признаки заболевания. Помимо полового пути передачи заражение болезнью возможно в детском возрасте, во время родов.
Такой путь называют вертикальным, и реализуется на практике он нечасто.
Реже всего заражение происходит из-за контактно-бытового пути передачи. Это значит, что человек не соблюдает базовые правила гигиены, пользуясь чужими полотенцами или бельем.
Если хозяин гигиенических принадлежностей болен, то и использующий зараженные предметы также заразится.
Уреаплазмоз: причины болезни
Многие задаются вопросом о том, что именно вызывает проявления болезни у различных людей.
Следующие факторы способствуют появлению симптомов:
- различные сопутствующие патологии, передающиеся половым путем, осложнит уреаплазмоз, если пациент является носителем заболевания и параллельно заражается еще какой-либо болезнью аналогичной природы;
- развитие иммунодефицита способствует появлению симптомов, причем, чем ниже иммунитет, тем ярче будет клиническая картина болезни;
- наличие дисбактериоза влагалища у представительниц прекрасного пола, приводящее к нарушению баланса в микрофлоре может способствовать активному размножению возбудителей;
- длительное применение антибиотиков или неправильное лечение народными средствами по поводу других болезней может привести к появлению симптомов;
- уреаплазмоз при беременности диагностируется гораздо чаще из-за того, что процесс вынашивания ребенка и так является стрессом для организма, а в условиях постоянного действия неблагоприятной внешней среды негативное воздействие только усиливается.
Врачи отдельно выделяют ВИЧ в качестве фактора появления заболевания. Конечно, вирус иммунодефицита относится к инфекциям, передающимся половым путем. Но опасность ВИЧ настолько высока, что его выделяют, как отдельный фактор риска.
Уреаплазмоз: симптоматика у мужчин и женщин
Поскольку заражение уреаплазмой часто является последствием иных заболеваний, поставить диагноз только по симптомам нельзя. Однако любой человек должен знать о типичных признаках, при появлении которых лечащий врач может заподозрить заражение бактерией.
Среди них:
- появление выделений у мужчин из уретры (отделяемое обычно скудное, часто мутное, но может иметь и прозрачный цвет);
- появление обильных, часто желтых или зеленых выделений из влагалища у женщин, которые как раз и заставляют обратиться к врачу;
- болезненность в нижней части живота в том случае, если инфекция проникает вглубь организма;
- жалобы на неприятные ощущения, среди которых обычно фигурируют зуд и жжение, появляющиеся при попытках облегчить мочевой пузырь;
- признаки раздражения во влагалище или в области полового члена.
Все эти признаки неспецифичны для патологии. А потому необходимо обязательно обращаться к врачу, а не заниматься лечением народными средствами.
Подобные симптомы могут свидетельствовать не только об уреаплазмозе. Но и о большом количестве других инфекций, передающихся половым путем. Только медицинский работник может решить, надо ли лечить заболевание и, если да, то как лучше это делать.
Лечить или не лечить заболевание, если оно диагностируется при беременности, интересуются многие женщины у своих гинекологов. К сожалению, даже сейчас врачи не могут ответить на этот вопрос однозначно и расходятся во мнениях на счет того, что есть норма, а что – патология. Даже на концентрацию возбудителя в организме опираться не получается.
Так как данные о воздействии микроорганизма на беременную очень разнятся. Считается, что существует связь между заражением уреаплазмозом и воспалительными процессами в плодных оболочках.
Эту связь удалось выявить в 50% случаев. Однако вместе с тем есть большой процент женщин, которые никак не страдают от уреаплазмоза. Хотя он был выявлен у них в беременность. При выкидыше многие врачи склонны грешить на эту бактерию.
Однако достоверных данных, которые позволили бы связать выкидыш и заражение микроорганизмом, не существует. В идеале при планировании беременности женщине рекомендуется пройти диагностику на это заболевание. Если результат анализа окажется положительным, прежде чем забеременеть, инфекцию стоит пролечить. Используют Вильпрафен или другие лекарства, рекомендованные лечащим врачом.
Планируя аборт, также стоит убедиться, что отсутствует заражение уреаплазмой. Так как она может вызвать неприятные последствия после процедуры. Как и в случае с беременностью, по возможности рекомендуют пролечиться перед процедурой, используя Вильпрафен или иные препараты.
Нужно ли лечиться при уреаплазмозе
Стоит ли лечить уреаплазмоз, если заболевание диагностировано у пациента, интересуются больные. Как и в случае с беременностью, мнения врачей в этом вопросе разнятся.
Исследования относительно необходимости терапии ведутся уже более 50 лет, а однозначных результатов все еще нет. Норма или нет нахождение бактерии в организме, необходимо решать в каждом случае индивидуально.
Объясняется это тем, что она относится к классу условно-патогенных. И проявляет себя только при определенных обстоятельствах.
С другой стороны, если инфекция присутствует в организме – это не норма, даже если она себя не проявляет. Более того, никогда нельзя сказать точно, когда появятся симптомы.
И не возникнет ли какое-либо осложнение, если терапии не уделить внимание. Сегодня медиками принято решение о том, что уреаплазмоз необходимо подвергать лечению.
Используя Вильпрафен или иные медикаменты только в том случае, если концентрация микроорганизмов по результатам анализов зашкаливает.
Если же концентрация не превышает отметку в 10 в 4 степени, то терапия не применяется, и пациент остается под врачебным наблюдением.
Способы терапии уреаплазмоза
Вылечить уреаплазмоз возможно, особенно если уровень патогенных микроорганизмов в теле человека превышает все допустимые границы нормы.
Основная причина активного размножения патогенов кроется в снижении иммунитета. Поэтому первое, что необходимо сделать врачу – это восстановить иммунную систему организма.
Подобную терапию называют подготовительной. Она назначается до приема пациентом антибиотиков.
Избавляться от заболевания народными средствами нерационально. Большинство лекарств, которые предлагает традиционная медицина, способны только заглушить симптомы.
Но при этом они никак не воздействуют на возбудитель. Естественно, размножение патогена продолжается. Организм повреждается, а человек не знает об этом, потому что заглушил тревожные симптомы.
Риск столкновения с осложнениями в этом случае многократно возрастает.
Часто применяемые схемы лечения уреаплазмоза
Назначение антибиотиков – обязательная часть лечения уреаплазмоза. Каждому человеку препараты подбираются в индивидуальном порядке. Могут назначаться в виде таблеток, уколов, свечей или в иных формах. Чаще всего применяются таблетированные формы, так как они наиболее просты в использовании.
В ходе лечений могут использоваться:
- Доксициклин, который в первые сутки принимают в дозировке 200 мг, а потом еще 13 дней ежедневно пьют по 100 мг;
- Макропен – препарат применяется по три таблетки ежедневно, при этом курс терапии составляет в среднем 10 дней;
- Эритромицин – медикамент, который используют либо по 500 мг дважды в сутки в течение 10 дней, либо по 250 мг четырежды в сутки тем же курсом;
- Вильпрафен или Джозамицин также может назначаться, причем курс и дозировка подбираются индивидуально.
Важно помнить, что только Вильпрафен или любой другой из антибиотиков, применяемые без предварительных анализов, не окажут влияния. Напротив, они могут только усугубить болезнь. Уреаплазмоз излечим только в том случае, если терапией занимается грамотный в своем деле врач!
Почему лечение уреаплазмоза прошло безуспешно
У человека, вылеченного от патологии, обычно не возникает новых вопросов.
А вот что делать тому, чья терапия уреаплазмоза не увенчалась успехом?
Прежде всего необходимо определить причину неудач.
Чаще всего проблема кроется в:
- несоблюдении рекомендации относительно длительности использования и режима дозирования назначенных антибиотиков;
- отсутствии полового воздержания в период лечения (особенно опасны контакты с партнером, который не получал лечение по поводу этого бактериального заболевания);
- неправильный выбор антибактериальных препаратов (к некоторым антибиотикам уреаплазма проявляет устойчивость, и применение их для терапии только усиливает невосприимчивость бактерии к медикаментам и именно из-за этого нельзя самостоятельно назначать себе антибиотики).
Важно помнить о том, что при повторном заражении уреаплазмоза нельзя назначать те же препараты, которыми пациент уже лечился ранее! Подобная ошибка способствует развитию устойчивости.
Соответственно, пациенту нельзя самостоятельно пить те же антибиотики, если он один раз уже справился с болезнью, и тут развился рецидив.
Терапия уреаплазмоза – непростая задача, которую должен решать компетентный в своем деле медицинский работник!
При подозрении на уреаплазмоз обращайтесь к грамотным венерологам и гинекологам.